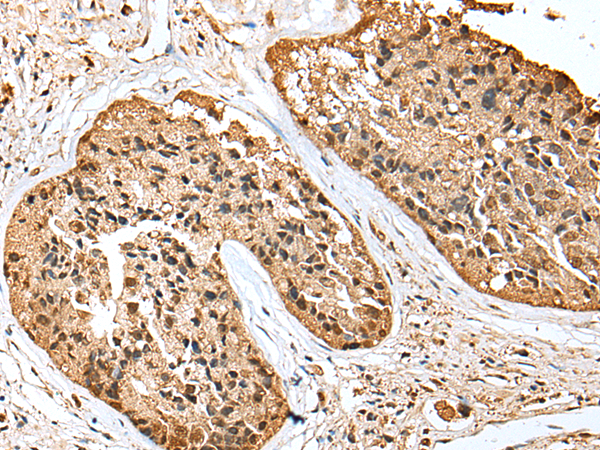

-
分类: 科研抗体货号: P11545别名: CIA; CGI-98; HSPC146应用: WB反应种属: Human, Mouse
-
分类: 科研抗体货号: P11524别名: TSP; THBS; TSP1; TSP-1; THBS-1应用: IHC反应种属: Human, Mouse
-
分类: 科研抗体货号: P11564别名: bHLHe76应用: IHC反应种属: Human, Mouse, Rat
-
分类: 科研抗体货号: P11544别名: p100; ASC1p100应用: WB反应种属: Human, Mouse
-
分类: 科研抗体货号: P11523别名: CT; KC; CGRP; CALC1; CGRP1; CGRP-I应用: IHC反应种属: Human
-
分类: 科研抗体货号: P11563别名: DED; BFR2; CHE1; CHE-1应用: WB反应种属: Human, Mouse, Rat
-
分类: 科研抗体货号: P11543别名: H5; ARTS; MART; SEP4; CE5B3; SEPT4; PNUTL2; hucep-7; BRADEION; C17orf47; hCDCREL-2应用: IHC反应种属: Human
-
分类: 科研抗体货号: P11522别名: DGK; DAGK2; DGK-BETA应用: IHC反应种属: Human, Mouse, Rat
-
分类: 科研抗体货号: P11561别名: FEB3; FHM3; NAC1; SCN1; SMEI; EIEE6; FEB3A; HBSCI; GEFSP2; Nav1.1应用: IHC反应种属: Human, Rat
-
分类: 科研抗体货号: P11542别名: EVN; NBN; ENOVIN应用: WB反应种属: Human, Mouse

鄂公网安备42018502007531号
鄂公网安备42018502007531号

